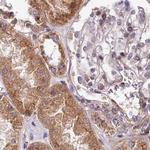
SPRYD3 Antibody in Immunohistochemistry (IHC)

Search
Invitrogen
SPRYD3 Polyclonal Antibody
{{$productOrderCtrl.translations['antibody.pdp.commerceCard.promotion.promotions']}}
{{$productOrderCtrl.translations['antibody.pdp.commerceCard.promotion.viewpromo']}}
{{$productOrderCtrl.translations['antibody.pdp.commerceCard.promotion.promocode']}}: {{promo.promoCode}} {{promo.promoTitle}} {{promo.promoDescription}}. {{$productOrderCtrl.translations['antibody.pdp.commerceCard.promotion.learnmore']}}
产品信息
PA5-58784
种属反应
宿主/亚型
分类
类型
抗原
偶联物
形式
浓度
规格
纯化类型
保存液
内含物
保存条件
运输条件
RRID
产品详细信息
Immunogen sequence: LARKDYPKNR HPGWSRGSVA YHADDGKIFH GSGVGDPFGP RCYKGDIMGC GIMFPRDYIL DSEGDSDDSC DTVILSPTAR AVRNVRNVMY LH
Highest antigen sequence identity to the following orthologs: Mouse - 100%, Rat - 100%.
靶标信息
The SPRY domain-containing protein 3 (SPRYD3) is a member of a family of proteins whose sole common characteristic is the presence of a SPRY domain. SPRY domains are structural domains that were first described in the fungal Dictyostelium discoideum tyrosine kinase spore lysis A. In most systems SPRY domains provide binding sites for regulatory proteins or intramolecular binding sites that maintain the structural integrity of a protein. Little is known of the function of the SPRYD3 protein.
仅用于科研。不用于诊断过程。未经明确授权不得转售。
篇参考文献 (0)
生物信息学
蛋白别名: SPRY domain-containing protein 3; unnamed protein product
基因别名: BC008150; SPRYD3
UniProt ID: (Human) Q8NCJ5
Entrez Gene ID: (Human) 84926, (Mouse) 223918